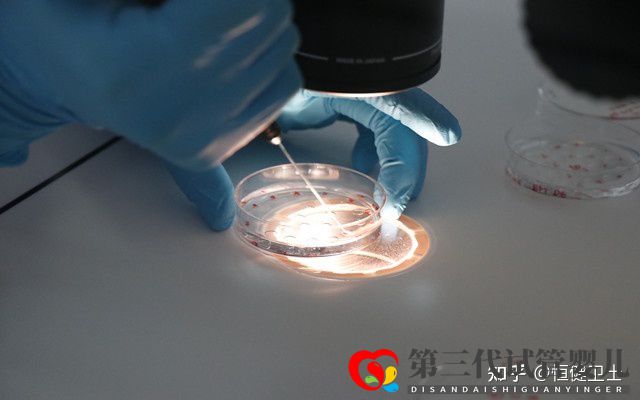
做三代試管大約多少錢一次(圖4)

做三代試管大約多少錢一次
目前國內做三代試管的價格在10-16萬左右。國外比如泰國費用在15-20萬左右。但是現在的疫情情況,大多數人可能在國內做三代。所以至少準備15萬,預備最好多一點,有備無患。


影響三代試管費用的三個因素
第一種:年齡
如果說你年輕,年齡大概在25-33歲左右,卵巢功能較好,卵泡的數量和質量是有保障的,成功率就會高一些,只需花費一個試管周期的錢即可。如果你的年紀大,卵巢功能嚴重下降,卵泡難以發育,用藥多,那自然就貴。
第二種:試管技術
如果你在三代試管過程中,還需使用到卵胞漿內單J子注射(二代試管),那么費用也會增加。
第三種:醫院的選擇
我們知道,醫院有公立和私立,公立是非營利性的,而私立呢是營利性的,公立醫院要有指征,大多數人不能做的,而私立有綠色通道比較容易,但是,花費也比較高。
如何一步一步提高試管成功幾率?
第一個首先是卵子的品質
卵子是試管最基礎的物質之一,質量越高,那么后面配對成胚胎的數量和等級就有越高的機會,最好的辦法就是盡量選擇合適的年齡進行試管,女人超過35歲,卵子品質開始老化,成功幾率會打折,所以呢做試管要越早越好。

第二個是子宮內膜的品質
子宮內膜是胚胎成長、發育的重要場所,內膜如果適合、血流豐富而且細胞分裂良好,會增加著床率,移植前如果內膜不達標,可以先將胚胎冷凍,等情況合適后再植入,可以增加試管成功的幾率。
胚胎植入之后要適當的臥床休息,以及補充足夠的黃體酮,以增加著床率減少宮外孕的比率。
第三個是胚胎植入手術
胚胎培育好之后,要移植回女性的子宮,這個過程決定著試管嬰兒能否正常著床。如果醫生將胚胎放在容易著床的位置,可增加成功幾率,因此經驗豐富、技術精湛的專家很重要。





